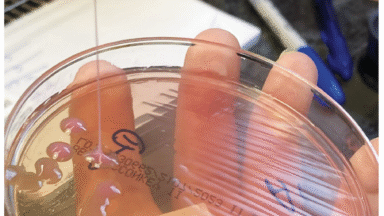

Figma is making significant strides in India by launching a local office and recruiting local talent, aiming to enhance its connection with one of its largest user bases. The company, which revolutionized design tools with its browser-based platform, is now setting its sights on developers, who represent a vital part of its future growth strategy. Founded in 2012 by Dylan Field and Evan Wallace, Figma has become a preferred collaboration platform for UX and product teams, overcoming initial skepticism about its cloud-based approach. With approximately 33% of its users being developers, the company is rolling out features designed to integrate design with engineering workflows, but it faces challenges in changing perceptions among Indian developers who view Figma primarily as a design tool. Abhishek Mathur, the VP of Engineering at Figma, emphasized the potential in India, stating, "India has such a large population of developers who might not currently think of Figma as their tool, and that’s the thing that we want to do." He highlighted the company's commitment to fostering community engagement and showcasing how developers can utilize Figma beyond just coding. The recent inauguration of Figma's office in Bengaluru marks a pivotal moment in its expansion efforts outside the United States. Previously, the company supported Indian users remotely from Singapore but now recognizes the importance of establishing a local presence in a rapidly growing market. Mathur noted that international users account for 85% of Figma's overall engagement, with India being its second-largest market after the U.S. Figma's reach is extensive, serving users across 85% of India's official states, and over 40% of the top 100 companies listed on the Bombay Stock Exchange are Figma clients. The platform currently boasts 13 million weekly active users globally, with India representing a substantial portion of this base, including a community of over 25,000 members known as Friends of Figma. In May, Figma launched AI-driven features to broaden its appeal beyond design teams, positioning itself against competitors like Adobe and Canva, as well as AI coding platforms. One notable feature, Figma Make, enables users to create web applications using natural language prompts, significantly enhancing collaboration between design and development. The Bengaluru office will initially bolster sales and marketing efforts, targeting a diverse clientele that includes startups like CRED and Swiggy, as well as large IT service providers like Infosys and TCS. In 2024, Figma generated around half of its revenue from international markets, with India being highlighted as a critical area for growth. The feedback from the Indian user community is already shaping Figma's product development, leading to enhancements such as improved code-export features to meet the demands for higher-quality outputs. Mathur stated, "We want to continue to do events, understand and work with our customers — small to large — and as time progresses, we might add other possibilities as well."
OpenAI is set to incorporate advertisements into its ChatGPT platform, aiming to enhance the user experience while gener...
CNN | Jan 16, 2026, 20:15
TikTok has made a subtle yet significant move by launching PineDrama, a dedicated micro drama app, in the United States ...
TechCrunch | Jan 16, 2026, 21:50
In a significant legal development, a federal judge has issued a default judgment against Anna’s Archive, the controvers...
Ars Technica | Jan 16, 2026, 21:45
The ongoing memory shortage spurred by advancements in AI technology is poised to become a significant narrative in the ...
Ars Technica | Jan 16, 2026, 20:05
In a startling medical case, a 63-year-old man from New England presented to the hospital with fever, cough, and alarmin...
Ars Technica | Jan 16, 2026, 21:35